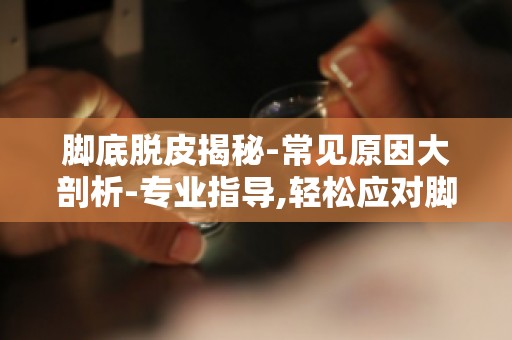

脚底脱皮揭秘-常见原因大剖析-专业医师解析,脚部脱皮背后的原因
脚底脱皮是许多人生活中常见的皮肤问题,轻则影响美观,重则可能引起不适。了解脚底脱皮的原因,对于预防和治疗这一症状至关重要。本文将为您揭秘脚底脱皮的常见原因,帮助您更好地保护自己的脚部健康。

1. 湿疹引起的脚底脱皮
湿疹是一种常见的皮肤病,其特征是皮肤炎症、瘙痒和脱皮。当湿疹发生在脚部时,会导致脚底皮肤出现脱皮现象。湿疹的原因包括遗传、环境因素、过敏反应等。研究发现,湿疹患者的皮肤屏障功能受损,使得皮肤更容易受到外界**,从而导致脱皮。
2. 真菌感染导致的脚底脱皮
真菌感染是脚底脱皮的常见原因之一。足癣(俗称香港脚)就是一种由真菌引起的皮肤感染。真菌在温暖潮湿的环境中生长繁殖,容易侵袭脚部皮肤。感染初期,脚底可能出现红斑、瘙痒、脱皮等症状,如果不及时治疗,病情会加重。
3. 脚部摩擦引起的脚底脱皮
长时间穿着不合脚的鞋子,或者在行走过程中脚部受到摩擦,都可能导致脚底脱皮。摩擦会破坏皮肤的保护层,使得皮肤失去水分,变得干燥、脆弱,从而出现脱皮现象。
4. 脚部出汗过多引起的脚底脱皮
脚部出汗过多会导致皮肤潮湿,容易滋生细菌和真菌,从而引发脚底脱皮。潮湿的皮肤还容易受到摩擦和压迫,进一步加剧脱皮现象。
5. 脚部皮肤干燥引起的脚底脱皮
脚部皮肤干燥是导致脚底脱皮的重要原因之一。随着年龄的增长,皮肤水分流失加快,导致皮肤干燥。不良的生活习惯、缺乏适当的皮肤护理等也会导致脚部皮肤干燥,进而出现脱皮现象。
6. 脚部皮肤过敏引起的脚底脱皮
脚部皮肤过敏可能导致脚底脱皮。过敏原包括化妆品、洗涤剂、鞋垫等。当皮肤接触到过敏原时,会产生炎症反应,导致皮肤瘙痒、红肿、脱皮。
7. 脚部皮肤硬化症引起的脚底脱皮
脚部皮肤硬化症是一种罕见的皮肤病,其特征是皮肤增厚、硬化。硬化部位的皮肤容易出现裂口,导致脱皮。
8. 脚部皮肤癌引起的脚底脱皮
脚部皮肤癌在早期可能表现为脚底脱皮。如果脱皮伴随有疼痛、出血等症状,应及时就医,排除皮肤癌的可能。
9. 脚部皮肤损伤引起的脚底脱皮脚部皮肤受到损伤,如割伤、烫伤等,可能导致皮肤感染、炎症,进而引发脚底脱皮。
10. 脚部皮肤营养不良引起的脚底脱皮
营养不良会导致皮肤干燥、粗糙,从而出现脱皮现象。脚部皮肤营养不良可能与饮食不均衡、消化吸收不良等因素有关。
11. 脚部皮肤细菌感染引起的脚底脱皮
细菌感染可能导致脚部皮肤出现红斑、瘙痒、脱皮等症状。常见的细菌感染包括金黄色葡萄球菌、链球菌等。
12. 脚部皮肤病毒感染引起的脚底脱皮
病毒感染也可能导致脚部皮肤出现脱皮现象。例如,手足口病就是一种由肠道病毒引起的传染病,其特征是手足口部出现水疱、脱皮等症状。
脚底脱皮的原因多种多样,包括湿疹、真菌感染、摩擦、出汗过多、皮肤干燥、过敏、硬化症、皮肤癌、皮肤损伤、营养不良、细菌感染和病毒感染等。了解这些原因有助于我们更好地预防和治疗脚底脱皮。如果您发现自己的脚底出现脱皮现象,应及时就医,找出病因,采取相应的治疗措施。保持良好的生活习惯,做好脚部护理,也是预防脚底脱皮的重要途径。